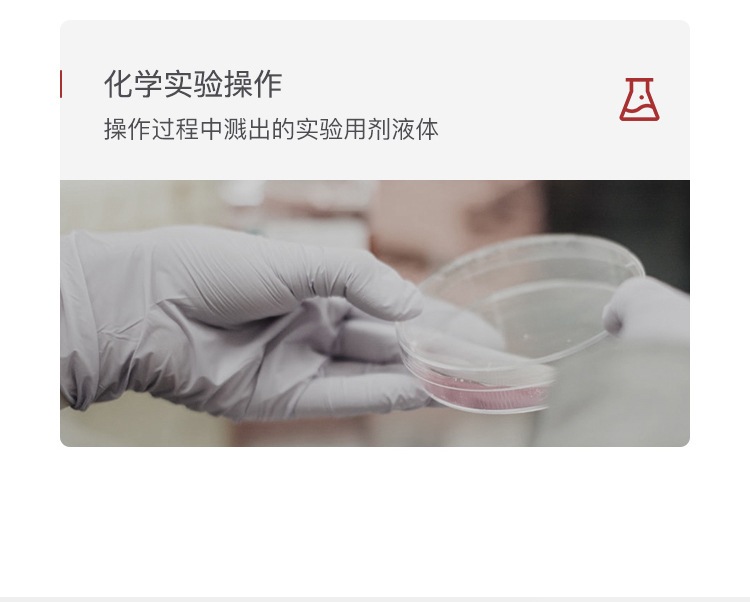

霍尼韦尔 护目镜 LG99200 透明 防刮擦 防冲击 1副
价格¥12.92 /副除新疆、西藏外含税含运费
未税价格¥11.43(税率:13%)
配送至
|包邮(顺丰/京东快递)...查看
浙江绍兴仓发货,下午4点前下单,两个工作日发货。
规格
 透明
透明
-
+

工牛价:是指普通会员最终购买商品的价格。
会员价或折扣价:是指与工品牛签署有效合同、对商品价格有特别约定的企业用户所享受的合同价格,可享的专属审批折扣价。
注①:企业用户同时满足协议价和会员价时,优先享受协议价。
注②:划线价格不代表商品原价
工品牛上的所有商品信息(包括但不限于商品图片、商品介绍、产品视频及文档)、产品咨询信息,是工品牛重要的经营资源,未经许可,禁止非法转载及使用。